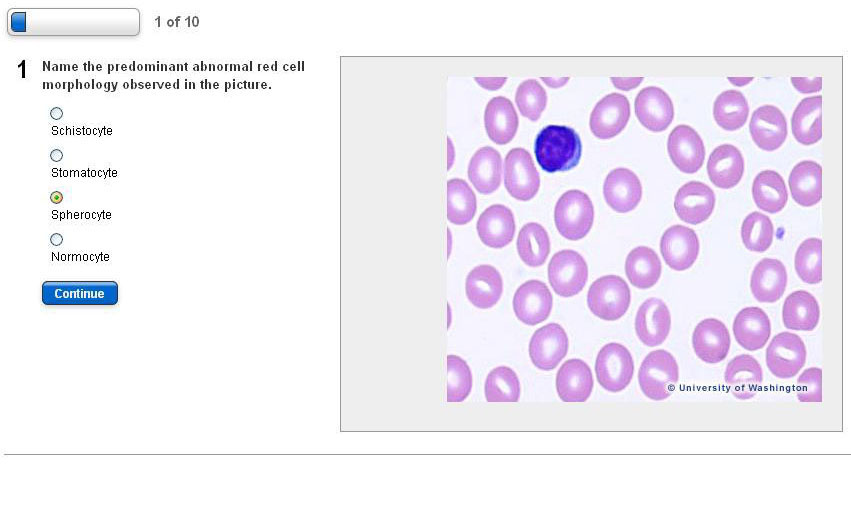

Hematology
Instructor:
Patricia Anderson, MT(ASCP); Michael Astion, MD,PhD; Drew Bell, PhD; Joyce Behrens, MS; Debbie Bremner; Wayne Chandler, MD; Jane Dickerson, PhD; Stacie Escott; Joanne Estergreen, MT(ASCP); Nancy Goodyear, PhD,MLS(ASCP)CM; Karin Harrison, BA; Kathleen W. Hutchinson, MS, MT(ASCP); Lisa Johnson, PhD; Adam Orkand, BA; Sherry Tsui, MLS; Sara Trimble, MS,MT(ASCP); Angela Vetch; Monica Wellner; Cynthia Wilcock, MS,C(ASCP)
Description:
This 10-question, multiple-choice assessment is designed to support clinical laboratory staff in meeting ongoing competency requirements. A new set of questions is published twice annually—on January 1st and July 1st—to ensure current and relevant content. The test is fully customizable and can be adapted to reflect the specific policies, procedures, and practices of your facility.
Learning Objectives:
No learning objectives specified for this training.